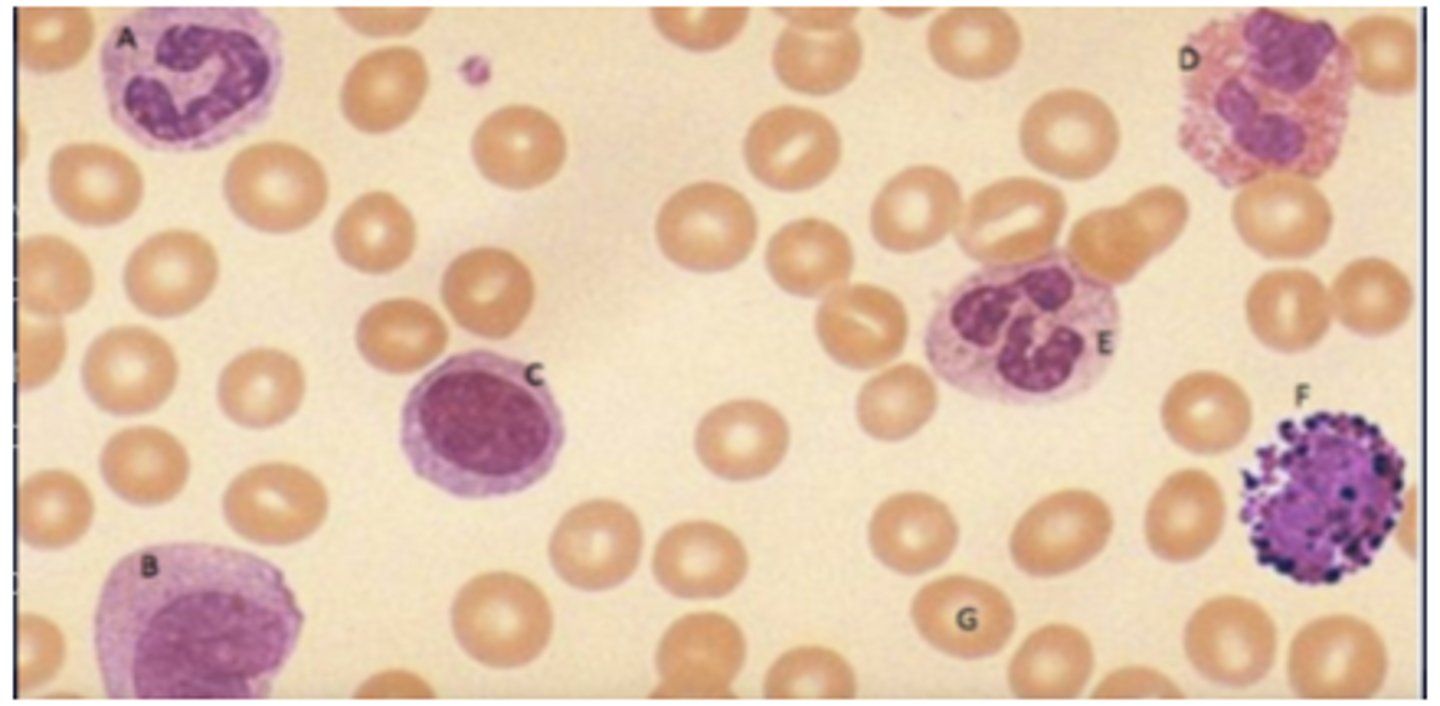
knowt flashcard image
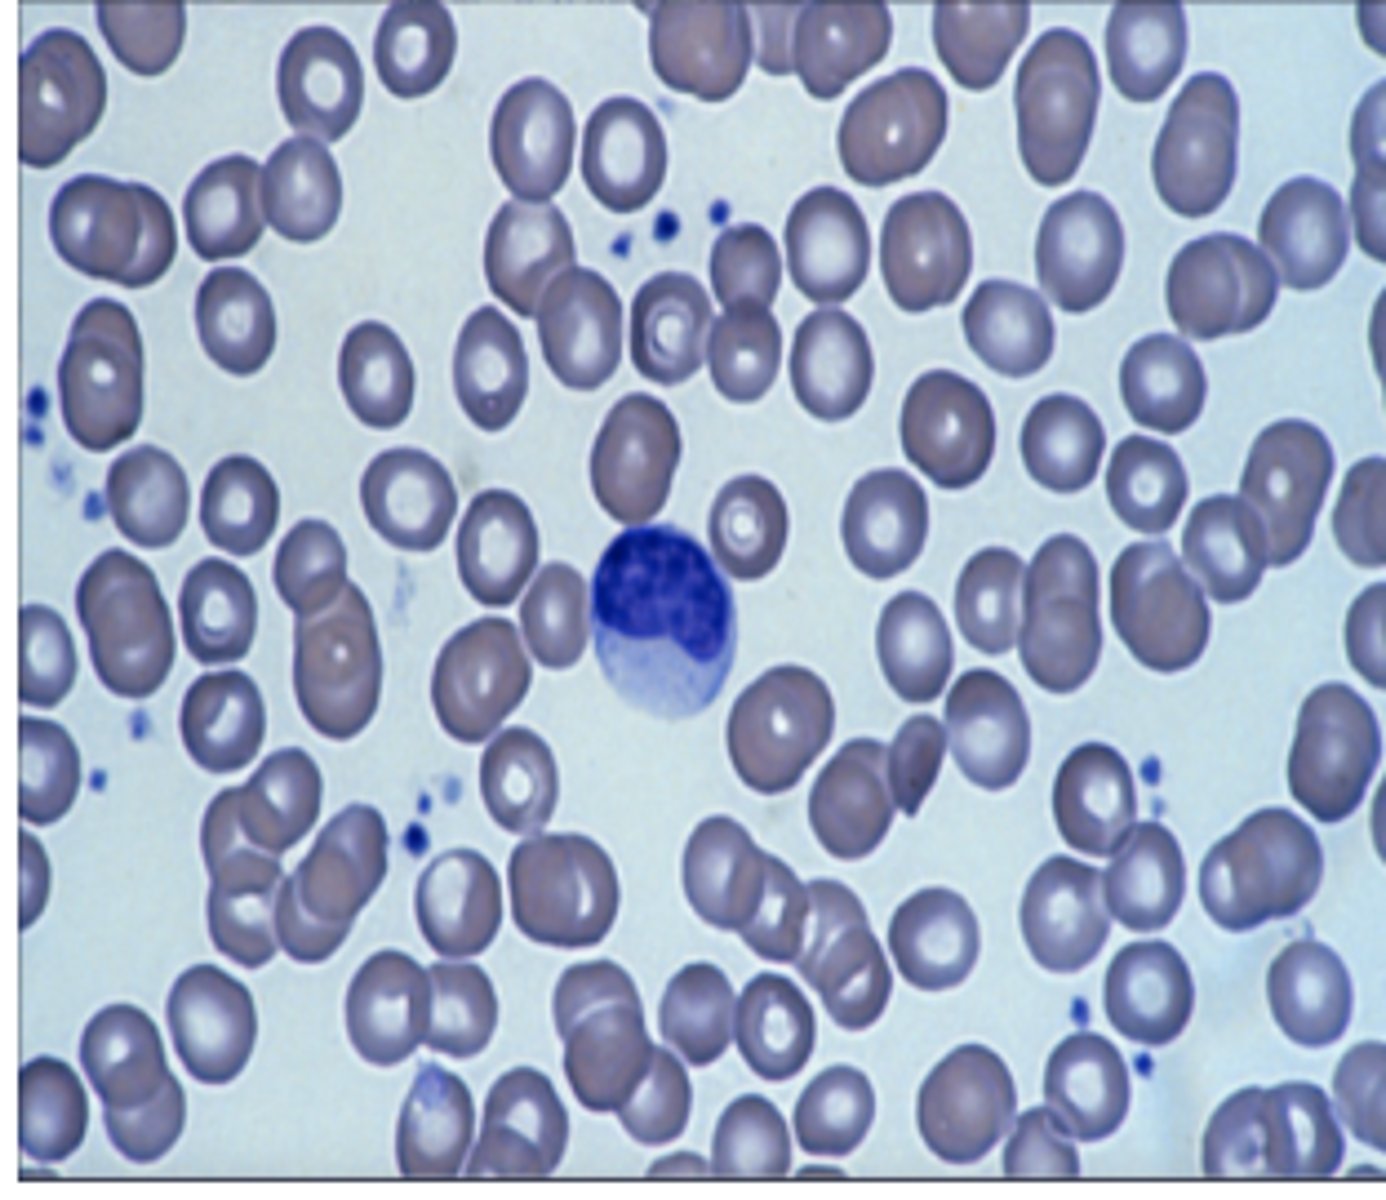
knowt flashcard image
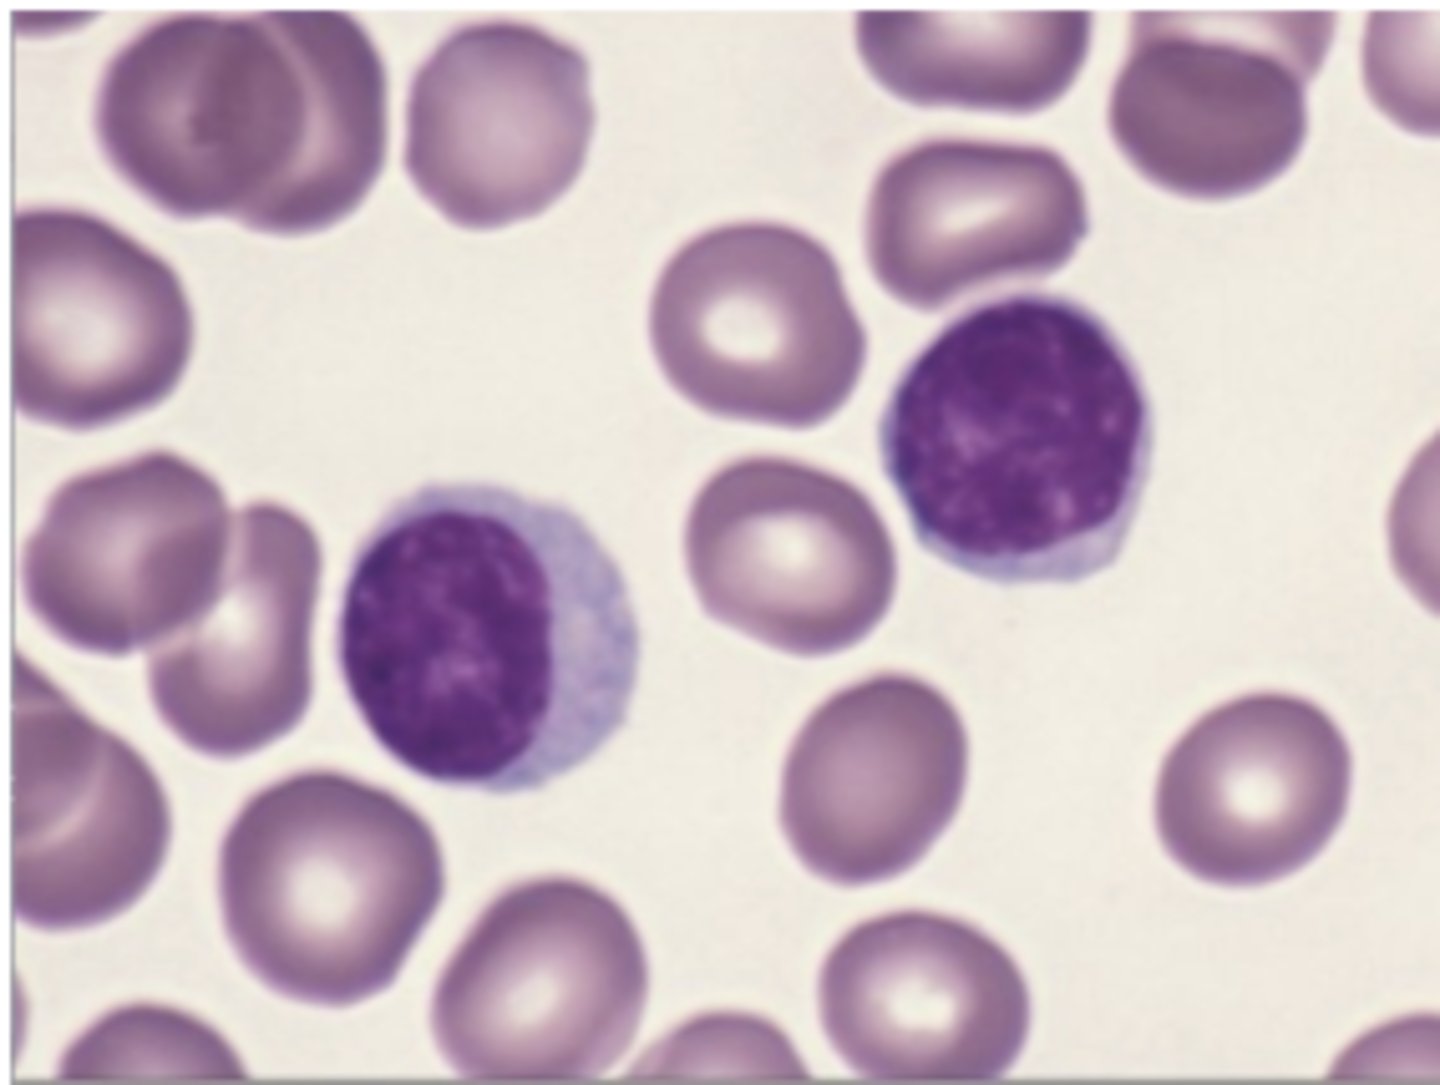
knowt flashcard image
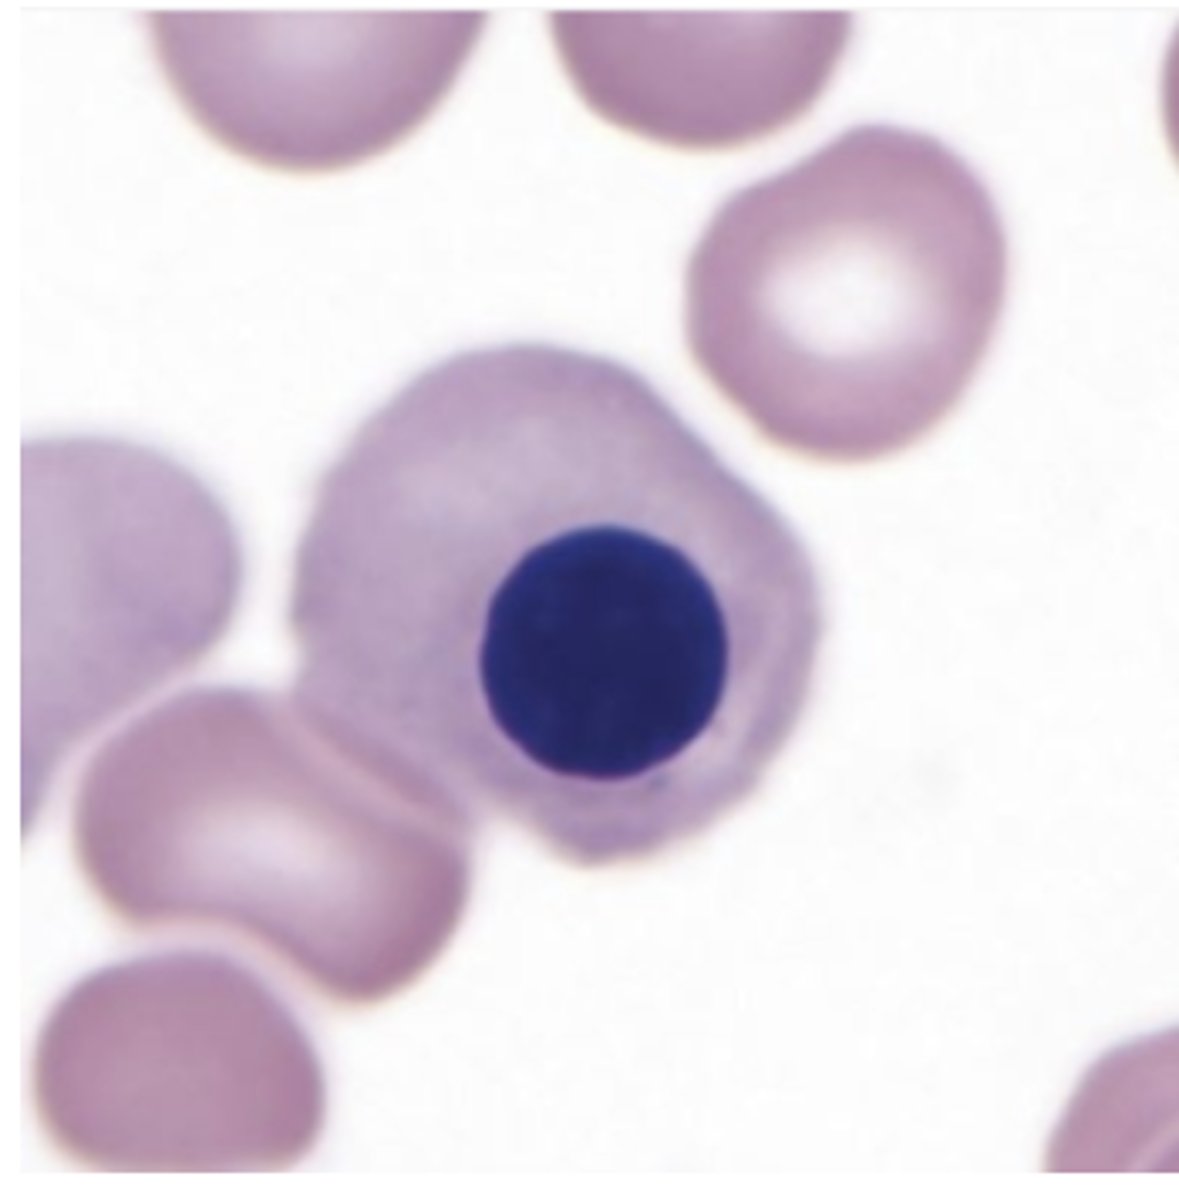
knowt flashcard image

Quiz Questions Exam 3-histology
1/77
There's no tags or description
Looks like no tags are added yet.
Name | Mastery | Learn | Test | Matching | Spaced |
|---|
No study sessions yet.
78 Terms
myelocyte
When are the specific granules produced at what stage?
platelet
These are formed by fragments of precursor cell cytoplasm?
Not sure, I put 12,000 leukocyte and 75 lymphocytes?? Could have been 75 neutrophil
Female labs, who shows a bacterial infection?
T lymphocyte
Which mature cell develops outside the bone marrow
neutrophil
Multilobed nucleus and pale staining cytoplasm
eosinophil
Bilobed nucleus and red stained cytoplasm
Red blood marrow and hematopoietic stem cell
All blood originates from one pluripotent stem cell in ___, named_____
erythrocyte
What cell stacks in to "rouleaux"
macrophage
Monocytes are the precursors for?
eosinophil
Which cells are involved in a parasitic infection?
A. band cell
B. monocyte
C. lymphocyte
D. eosinophil
E. neutrophil
F. basophil
G. erythrocyte
monocyte
lymphocyte
normoblast
promyelocyte

neutrophilic band cell

megakaryocyte

eosinophilic myelocyte

transitional/urothelium
What kind of epithelium is in the ureter?
glomerulus
What part of the nephron is responsible for the majority of filtration?
Lymph node
Which of the following organs has a paracortex?
Plasma cell to make antibodies
Main function of B cell in adaptive immunity?
Vasa recta
What is found only in the renal medulla?
T cell negative selection
What happens in the thymic medulla?
thymus
What doesn't have lymphatic nodule?
spleen
What has white pulp?
Hassall's corpuscle
What is found in medulla of thymus
B cell
Most abundant cell in lymph nodule?
ureter

Bowman's capsule

thin loop of henle

cortical labyrinth

X - proximal convoluted tubule

Hassall's corpuscle??

central arteriole

pharyngeal tonsil

circle around germinal center

lymph node

simple columnar
What kind of epithelium lines the gallbladder?
branch of hepatic artery, portal vein and bile duct
Portal triad?
Filliform papillae
What papillae is most numerous but lacks taste buds?
submandibular gland
gland with mucous cells and serous demilune below the mucous cells?
ameloblast
cell producing enamel
Hepatocytes, irregular plates
Main cell in the liver and form
Parietal/ oxyntic cells
What are the gastric gland cells responsible for HCL and intrinsic factor secretion?
Pancreas
Centroacinar cells exclusively from which of the following organs?
esophagus
What is the only organ of the alimentary canal with both skeletal and smooth muscle in its muscularis externa?
lacks villi
Mucosa of large intestine
paneth cells

green arrow = centroacinar cell

appendix

Brunner's gland

taenia coli

arrow = pyloric sphincter

Filliform papillae

parotid gland

masticatory mucosa

esophagus

secrete testosterone
Leydig cells do what?
Peg cells hypertrophy??
What happens during the estrogen phase of the menstrual?
Primary oocyte
What is arrested in prophase 1 in oogenesis
Spermatids mature to sperm during spermatogenesis
What is true?
Simple or pseudostratified columnar cells
Epithelia of prostate gland
Sertoli cells or spermatogonia???
What cells present in the basal layer of seminiferous tubules
Corpus cavernosum
What contributes to the main source of rigidity during an erection
Spermatogonia
Cell type responsible for producing sperm in seminiferous tubule
Increase secretion of endometrial gland
Histological events during secretory phase of the uterus during the menstrual cycle preparing the endometrium for potential embryo implantation
Yellow arrow = primordial follicle

B = endometrium

vaginal mucosa

Lactating mammary gland

red: corpora cavernosa

seminiferous tubules

epididymis

spermatozoa

seminal vesicle

Organ = prostate

primordial follicle
